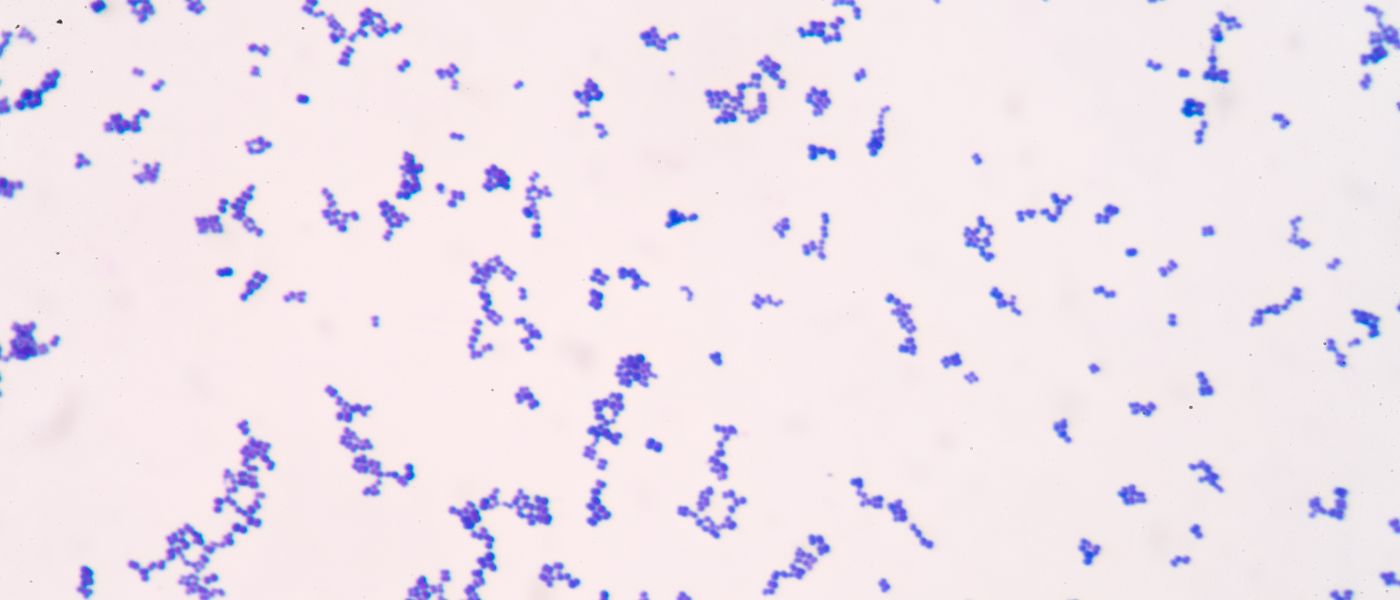

Reduce Gut Fermentation for SIBO Relief: Introducing the Prebiotic Bacteriophage
Key Points:
- SIBO stands for small intestinal bacterial overgrowth. It typically occurs when gut motility is slowed, giving bad bacteria more time to breed in the small intestine. SIBO is commonly associated with other chronic illnesses, particularly those that affect the gut.
- Common treatments for SIBO include restrictive diets, probiotics, and even antibiotics. While these may spark some positive results, we advocate for a more holistic approach to healing the gut ecosystem, including a low-fermented foods diet, a prebiotic bacteriophage supplement, and butyrate.
- At BodyBio, we’re always using the latest research in cellular health to help you optimize your health. That’s why we combined Preforpro prebiotic bacteriophage and postbiotic tributyrin to create a cutting-edge gut supplement that works with your gut ecosystem.
Sudden stomach pains, unexpected bathroom runs, and severe bloating…
Gut issues are extremely common and perhaps one of the most anxiety-inducing parts of many health conditions.
Maybe you’ve done the uncomfortable tests, tried every recommended diet, and tried every supplement out there — but no matter what, small intestinal bacterial overgrowth (SIBO) feels like it’s here to stay.
Change that limiting belief right now: SIBO is not a permanent illness.
We understand just how frustrating it can be to experience gut symptoms with little resources and practical support for treatment. SIBO is fairly unresearched and underdiagnosed, so getting the right care when you’re suffering can be extremely difficult.
But it’s not impossible.
With new advances in science and technology, breaking the cycle of SIBO may be easier than you think.
Here’s how we approach SIBO from a perspective informed by cellular health and microbiome research.
Table of Contents:
What is SIBO?
SIBO stands for small intestinal bacterial overgrowth. It occurs when unhealthy bacteria take over the small intestinal tract (where there should normally be little to no bacteria at all), wreaking havoc on the intestinal barrier and causing uncomfortable symptoms. Usually, SIBO is the result of a sluggish gut — food sticking around in the small intestine for too long, giving unhealthy bacteria time to ferment.
Over time, the unhealthy bacterial overgrowth may omit a type of gas: hydrogen, methane, or hydrogen sulfide-dominant gasses, depending on the bacteria present. These gasses will determine the symptoms associated with SIBO and may determine how SIBO is treated, too.
What Causes SIBO?
SIBO can result from overuse of antibiotics and other medications like birth control or SSRIs, or even from a physical trauma that dysregulates the nervous system. There are some cases where SIBO pops up without a specific trigger due to poor diet and lifestyle habits. But for the most part, SIBO accompanies other chronic illnesses like Crohn’s disease, Lyme Disease, irritable bowel syndrome, celiac disease, and more.
While research on SIBO is still limited, it’s estimated that up to 78% of irritable bowel syndrome patients also have SIBO. Since symptoms of SIBO are common in other gut-related illnesses, getting a proper diagnosis can be difficult. Luckily, if you suspect SIBO is the root cause of your symptoms, a simple breath test is all you need for an official diagnosis.
Types of SIBO
If you suspect SIBO, finding out which type you have is an important step in your healing journey. The dominant gas in your gut (hydrogen, methane, or hydrogen sulfide) can explain your unique symptoms and give you an individualized treatment plan.
Hydrogen Dominant SIBO
Characterized by symptoms of diarrhea, too-fast gut motility, gas, bloating, and overall abdominal discomfort, this type of SIBO is considered the most common. It’s diagnosed with a breath test that shows high levels of hydrogen in the body.
The goal of treatment is to lower hydrogen levels and return the gut to homeostasis. Typical treatment may look like antibiotics, a low-FODMAP diet, or herbal remedies to kick out the bad bacteria.
Methane Dominant SIBO
This type of SIBO is more commonly associated with symptoms of constipation, cramping, gas, bloating, and slower gut motility in general. Essentially, slowed digestion creates a breeding ground for unhealthy bacteria to take over. Some speculate that methane SIBO may coincide with a fungal overgrowth, like candida albicans. Over time, this overgrowth begins to cause symptoms.
Methane-dominant SIBO can be diagnosed with a breath test and may be commonly treated with antibiotics, probiotics, dietary changes, food eliminations, and herbs.
Hydrogen Sulfide Dominant SIBO
More recently discovered, hydrogen sulfide SIBO isn’t as well researched as other types of SIBO. But like hydrogen SIBO, it is more commonly associated with diarrhea, gas, and cramping. Diagnosis and treatment are similar to the other types of SIBO, although some medical professionals may also recommend a low-sulfur diet to help with symptom relief.
A New Paradigm for SIBO Relief
We’re always staying up-to-date on the latest research in cellular health and how it relates to the gut. For treating SIBO, many of our customers have found success with a combination of targeted supplements and dietary and lifestyle changes. Here’s a research-based strategy to finally kick SIBO to the curb for good.
1. Start a Low Fermentation Diet
Unhealthy bacteria can’t thrive and proliferate if they can’t eat. That’s the science behind the low-fermentation diet for SIBO — and for many, it works. When bad bacteria are starved out of the body, it creates space for healthy bacteria to thrive, returning the body to homeostasis.
The low fermentation diet isn’t as strict as the low FODMAP diet (also commonly recommended as a treatment for SIBO), so it’s easier to maintain long-term and doesn’t completely deprive the body of carbohydrates (which are important for energy and hormone regulation, especially for women).
Low Fermentation Foods
- Meat, eggs, and low-lactose dairy. The low-fermentation diet includes organic and grass-fed meat, eggs, and low-lactose dairy in moderate amounts. Fermented foods like yogurt and kefir aren’t recommended.
- Healthy carbs. Yep, carbs are allowed in the low-fermentation diet and are important to keep your energy and hormone levels balanced. Try to stick with carbs that are healthy and easy to digest, like rice, sweet potatoes, or quinoa.
- Fruits and veggies. Except for cruciferous veggies and dried fruits, there aren’t any fruits or vegetables you should eliminate from the low-fermentation diet. You may want to prioritize cooked veggies at first though, if your symptoms are flaring. These will be easier to digest and absorb nutrients through the gut lining.
- Nuts and seeds. Full of protein and healthy fats, nuts and seeds are a great snack and perfectly acceptable for the low-fermentation diet (allergies notwithstanding, of course). You can add any healthy fats to your diet, like avocados, salmon, olives, and natural almond butter.
2. Try a Prebiotic Bacteriophage to Create Balance in the Gut
Probiotics may be recommended as part of the treatment plan for SIBO. But we’ve found that probiotics often don’t make a lasting difference in your gut ecosystem. Maybe you’ve noticed this in your healing journey, too.
Without testing, it’s impossible to know which strains of probiotics your gut needs to promote wellness. And throwing the dart with large numbers of probiotic strains may do more harm than good for your gut in the long-term.
That’s why we prefer to focus on prebiotics and postbiotics for SIBO healing (and overall gut health). Prebiotics supply food for healthy bacteria, giving them nourishment to thrive. Postbiotics work to repair gut lining damage (aka leaky gut) while strengthening cells in the gut.
Your gut microbiome is as unique as your fingerprint. There’s no way a broad-spectrum probiotic supplement can perfectly mesh with your specific microbiome and supply the exact strains you need for healing. By turning our attention to the elements that allow healthy bacteria to thrive (prebiotics and postbiotics), we give power back to our bodies.
The Problem with Traditional Prebiotics
While prebiotics (aka fiber) are often recommended for those with gut issues, they could actually do more harm than good if recommended for SIBO. Prebiotics are food for bacteria to ferment, and slow fermentation is one of many factors that can make SIBO symptoms worse (which is why we love the low fermentation diet). Fortunately, there’s a new type of prebiotic that doesn’t cause uncomfortable gas and bloating.
What Is a Bacteriophage? Creating Balance in the Gut
Enter the prebiotic bacteriophage: A bacteriophage (or “phage” for short) is a naturally occurring DNA or RNA element found in soil, fermented foods, and yes — humans. Phages have one simple job, to target and eliminate bacteria. We can use these phages in our favor — to destabilize bad bacteria, leaving space for microorganisms to get the nutrients and space they need to thrive.
Prebiotic bacteriophages are much faster-acting than regular prebiotics, too. So when you use them, you’ll likely see results in days rather than weeks.
3. Butyrate to Repair the Gut Lining
Butyrate is a postbiotic that helps to strengthen cells in the gut while repairing any damage or leakage in the gut lining. For many, butyrate is used to improve symptoms of gas, bloating, and constipation — which is particularly helpful when fighting SIBO (which thrives on slow gut motility).
Butyrate has a number of other benefits, too. It helps to support a healthy inflammation response and to boost the immune system.* As a whole, butyrate provides a key component to healing SIBO from the inside out.
We Combined PreforPro Prebiotic Bacteriophage and Tributyrin Butyrate for Ultimate Gut Health
Although interventions like dietary changes and probiotics may provide some initial symptom relief, they rarely finish the job when it comes to fighting off bad bacteria. After years of cutting-edge research and support to help BodyBio customers heal SIBO with our trusted Butyrate supplement, we created the ultimate gut supplement that does it all. A Super Butyrate, if you will.
Gut+ is a postbiotic, prebiotic, and bacteriophage all in one. We created it to support regularity and digestion, while gently cleansing the body of SIBO-causing bacteria.
If you’re ready to support your whole gut ecosystem without massive interventions like antibiotics or overly restrictive diets, it’s time to add Gut+ to your supplement routine. For more information, check out our Gut+ Get Started Guide or simply...
References
Ghoshal, U. C., Shukla, R., & Ghoshal, U. (2017). Small Intestinal Bacterial Overgrowth and Irritable Bowel Syndrome: A Bridge between Functional Organic Dichotomy. Gut and liver, 11(2), 196–208. https://doi.org/10.5009/gnl16126
Sivaprakasam, S., Prasad, P. D., & Singh, N. (2016). Benefits of short-chain fatty acids and their receptors in inflammation and carcinogenesis. Pharmacology & therapeutics, 164, 144–151. https://doi.org/10.1016/j.pharmthera.2016.04.007
Ruscio M. (2019). Is SIBO A Real Condition?. Alternative therapies in health and medicine, 25(5), 30–38.
Kiani, A. K., Anpilogov, K., Dautaj, A., Marceddu, G., Sonna, W. N., Percio, M., Dundar, M., Beccari, T., & Bertelli, M. (2020). Bacteriophages in food supplements obtained from natural sources. Acta bio-medica : Atenei Parmensis, 91(13-S), e2020025. https://doi.org/10.23750/abm.v91i13-S.10834